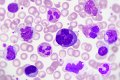

Профессор Злата Григорьевская перечислила анализы крови, результаты которых могут указать на возможное развитие рака, и расшифровала их значения. Медик в интервью «АиФ» отметила, что исследования, которые делают в поликлиниках, могут сигнализировать об онкологическом заболевании и помочь диагностировать его на ранних стадиях.
Эксперт отметила, что самый информативный анализ — это анализ крови. По ее словам, врачей должно насторожить, если изменена скорость оседания эритроцитов (СОЭ). «Причиной этого может быть не только сезонное ОРВИ и обострение хронических заболеваний, но и онкологическое заболевание. Поэтому повышение скорости (у мужчин — выше 15-20 мм/ч, у женщин — выше 20-30 мм/ч) должно стать поводом для более детального обследования», — обратила внимание Злата Григорьевская.
Изменение уровня лейкоцитов (резкое повышение или снижение) медик также назвала признаком возможной болезни. Нормальное значение у взрослых — 4-9×10*9 Ед/л. Стоит беспокоиться, по словам эксперта, и из-за изменения уровня общего белка: опухоли активно потребляют его, из- за чего его уровень в крови обычно снижается. В таком состоянии у многих пациентов пропадает аппетит, и уровень белка снижается еще более ощутимо, утверждает Григорьевская.
«Опухолевые клетки тормозят выработку инсулина. В ответ на это организм повышает концентрацию глюкозы в крови. Из-за этого у некоторых пациентов до появления симптомов рака возникают признаки сахарного диабета, — акцентировала внимание профессор. — Повышение уровня сахара в крови особенно часто отмечается при саркомах, раке легких, печени, органов раке молочной железы и матки. Нормальные значения глюкозы — от 3,5 до 6 ммоль/л».
Повышение уровня АлАт (АЛТ) в крови — также один из тревожных сигналов. Фермент может повышаться при опухолях в печени, добавила медик. Для дополнительного обследования следует проконсультироваться с гепатологом и онкологом. «Нормальные значения АЛТ: мужчины — до 45 ед/л, женщины — до 31 ед/л», — отметила Злата Григорьевская.
Высокий уровень мочевины в крови говорит об ухудшении работы почек или активном распаде белка, и с этим, по словам врача, следует обратиться к урологу, который назначит дополнительные обследования. Избыток же щелочной фосфатазы в крови может говорить об опухолях и метастазах костей, поражения печени, желчного пузыря. «Нормальные значения: мужчины и женщины старше 19 лет — 40–150 ед/л», — рассказала профессор.
Ранее доктор Мясников рассказал о продолжительном кашле, который может говорить о раке легких. Если человек бросил курить, а кашель еще больше месяца сохраняется, если появляются прожилки крови в отсутствии выраженного воспаления легких, надо обязательно делать КТ.
Дата: 27/04/2022 19:02:44
Прочитана раз: 46
Комментарии [0]